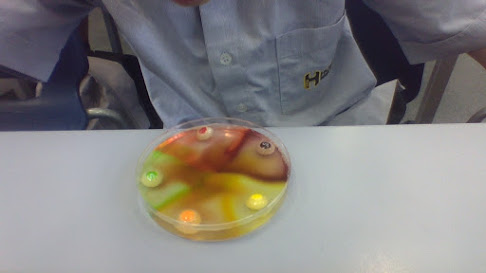

I am a Year 7 student in the Uru Mānuka Cluster. This is a place where I will share my learning. Please note that some of it will not be complete, it will be my first drafts. Remember to be positive, thoughtful and helpful when you leave me a comment.
Friday, December 3, 2021
Business & Enterprise (Bath Bombs & Bath Salts)
Friday, November 19, 2021
Moa Facts
Welcome this is a slide about Moas its lots of facts about them & A story also if you want the backgrounds i have go to slidescarnival on some of my slides i will have a slides carnival theme on also there are 3 facts and 1 story. Hope you like.
Friday, November 5, 2021
Longfin eel Facts
Hi and welcome to my blog post I have 4 facts about Longfin eels I used Google Slides and Slides Carnival you can get all sorts of different Google Slides backgrounds I have a water one on for my work because eels live in water, also just tap once on the water and it will work because it is animated!
Friday, September 24, 2021
Thursday, September 16, 2021
Chemicals
Red Cabbage Indicator Experiment
Materials :
1. Red Cabbage
2. Beaker
3. Bunsen Burner
4. Pipette
5. Sodium Hydroxide
6. Hydrochloric acid
7. Test Tubes
8. Paper Towel
9. Test tube rack
10. Water
Steps :
1. Chop up the red cabbage into small pieces. Place in a beaker and cover with a small amount of water.2. Bring the solution to the boil using a Bunsen burner and then turn off the heat. Let it sit to cool down.
3. Pour the cabbage water through a paper towel into a beaker. The dark purple liquid in the jar is the pH
5. Use the cabbage indicator and the pH chart below to test the acidity of the different 3 household liquids plus
Monday, September 13, 2021
Best Way to Cool Down Chilli in Your Mouth
Welcome to my Chilli Tasting Results Post this is about getting chilli out of your mouth faster
Aim: To see which the best way is to cool down the hot chilli taste in your mouth when eating chilli.
Hypothesis: I think milk is going to be the fasted way to get heat out of your mouth
According to google milk is the fasted way to get it away
Record : Yes or No
Immediately | After 3 minutes | |
Milk | It instantly lowers the heat but its not entirely gone | The heat was kinda gone |
Water | It Instantly turned down the heat a little bit | The heat was gone |
Coca Cola | It Completely removed the heat, but there was still a little bit of a sting | IT was gone |
Milk is the best way to call down your mouth water is usless and dont have beer or achol with it, it dos nothing
Sherbet
Welcome to my Sherbet post this is going to be about baking soda and things you can use it for
Hope You Like It!
These are ten things you can use baking soda for:
1. Scrub away scuff marks on the wall.
2. Deodorant.
3. Clean and unclog smelly sinks.
4. Cleans away mould.
5. Add abrasive to cleaning products.
6. Deoderise your kitty litter.
7. Clean your oven.
8. Wash build up in your hair.
9. Deoderise your carpets.
10. Laundry booster.
This is going to be the recipe of sherbet :
(need more sour, add more citric acid | need more sweetness or too bitter, add more icing sugar
1 tsp citric acid
1 tsp backing soda
1 Cup of icing sugar
1 tsp jelly crystals (any flavor)
Equipment
1. Teaspoons
2. Some to eat the sherbet with
3. 1 cup
Method
Add all the ingredients together in a mixing bowl or a cup or something and stir together.
And when you are finished you can eat it
Friday, September 10, 2021
Yeast/Ginger Beer
- What is yeast?
Yeast is fungi what can only be seen by a microscope but its all around us but we cant see it
There's natural yeast what is all around us, then there man made yeast in a bottle
Yeast produces Carbon dioxide (CO2)
Thursday, September 2, 2021
Boggle
Wednesday, September 1, 2021
Autumn Code Breaker -(Level 4)-
You had to answer the questions then turn them into the right letter.
Hope you like it!
--------------------------------------------------------------------------------------------------------------------------------
Friday, August 27, 2021
Lisa Carrington
Hope you like my Blog
(15 Questions That I Have Answered)
This is was Lisa was born in. Tauranga
This is the province of what city she was in. Auckland
This is Lisa’s iwi. Iwi Affiliations: Te Aitanga-a-Māhaki, Ngāti Porou. Finalist: Te Waitā Award for Sport.
This is the satellite town what Lisa grew up in. Whakatane
This is the High School Lisa attended. Whakatane
This is the name of her University Lisa went to and where it is located. Massey University in Alba
This is Lisa’s Olympic event. Summer olympics flatwater canoeing
These are 5 countries that Lisa has competed successfully in. Italy, Netherlands, France, Canada, Brazil
This is Lisa's crew mate in the Tokyo Olympics. Caitlin Regal
These are 2 awards Lisa has achieved in NZ. Supreme Award, Sportswomen Award
Lisa Carrington
Age: 32 Years old
Date-of-birth: 23 June 1989
Height: 1.68m
Weight: 63kgs (139lbs)
Sport: Kayak Sprint
Club: Eastern Bay Canoe Racing Club
MNZM means: New Zealand Order of Merit
Friday, August 13, 2021
NZ Olympic Athletes
Hello this is my blog about NZ Olympic Athletes i did this with my friend Jaden there will be a link to his blog at the bottom
Hope you like it
>>>Jaden's Blog
Thursday, August 5, 2021
Chilli Tasting
Hope you like it!

Thursday, July 29, 2021
Food Taste Test Recording
SAMPLE | Sweet, Sour, Bitter, Salty. | What did we think it was? |
A | Sweet | ? |
B | Salty | Salt |
C | Bitter | ? |
D | Sour | Malic acid powder |
E | Bitter | Onion |
F | Bitter | Raw potato |
G | Sweet | Apple |
H | Sweet | Lollie |
I | Sweet | Lollie |
Tokyo 2020 Olympics Tasks
Hello this is my blog about Olympics tasks there are 3 games with 5 facts also i'm going to add a link to the Olympic website. LINK>>>OLYMPICS WEBSITE
Hope you enjoy it!
Tokyo 2020 Olympics Tasks
(3x3 Basketball
35FACTS
Some 182 countries and regions join in the world competitions, and the number of players practicing the sport has more than 430,000.
8-team tournament Men & Women
3x3 basketball is an exciting sport. It developed from street basketball and is considered to be the world’s No. 1 urban team sport. In 2007, the International Basketball Federation (FIBA) formally adopted universal rules for 3x3 basketball ahead of its debut at the 2010 Youth Olympic Games (YOG) in Singapore.
However, the highlight of 3x3 basketball is its fast pace. There is no break after a goal or foul, and the team on offence must take a shot within 12 seconds from possession of the ball.
Coaches are not allowed to be at courtside, so players must build their own strategy. Players must also have good reflexes, coordination and vision as 3x3 basketball is a physically demanding sport with substitutions made frequently.
(Archery
5 FACTS
Archery dates back over 10,000 years, when bows and arrows were first used for hunting and warfare, before it developed as a challenging activity in medieval England. There are several variants, including target archery, where competitors shoot at stationary targets on a flat range; and field archery, which involves shooting at targets of varying and often unmarked distance, typically in woodland and rough terrain. This sport archery is an olympic sport, used in more than 140 countries around the world.
Individual competition (Men/Women) Team competition (Men/Women)
These individual elimination matches see the loser leave the competition and the winner goes to the next phase, until two people remain to contest the gold-medal match. The two semi-final losers compete for bronze.
If there is a tie after five sets (with a scoreline of 5-5), each athlete shoots a single arrow. The athlete whose arrow lands closest to the middle of the target wins the match — unless both athletes shoot a 10, whereby a second arrow is shot.
Team and mixed team matches are also decided using the set system, but each team set consists of six arrows and each mixed team set consists of four arrows rather than three. The first team or mixed team to five set points wins the match.
(Cycling BMX Racing
5 FACTS
BMX racing has its roots in the racing culture that started in California between the 1960s and 1970s. Influenced by motocross riders, children tried to imitate their heroes, but the sport remained relatively small until the 1980s. In 1982, the movie E.T. was released and helped popularise BMX racing mostly due to the famous final chase scene. That year the BMX bike became the “must have” bicycle for children and teenagers.
There are few rules other than the mandatory use of 20 inch wheels, but the increased exposure and popularity of the sport has led to innovations such as the use of carbon fibre frames, as competitors seek to gain an advantage to go faster.
BMX races are thrilling sprint races with a maximum of eight riders who launch themselves from a gate atop the 8m high 35-degree start hill. Riders can reach 60km/h while riding over alternating jumps and around banked corners.
The course is about 400m long and of all the five cycling events, this is the one in which riders need the most protective gear with a full-face helmet, gloves, goggles and long-sleeved protective clothing all used.
The most exciting places to watch are the corners. Riders will keep up their speed heading into these turns as they jostle for spots. This sometimes leads to collisions. However, even if riders do crash, it is still important for them to finish the race, with points awarded for crossing the finish line. The finish also makes for exciting viewing with both spectators and riders holding their breath to find out where they place in tight finishes.
Monday, July 26, 2021
Science again
2. Put the Bunsen Burner on the Heat mat.
3. Plug in the Bunsen burner in to the gas tap.
4. Put the Tripod over the Bunsen burner on the heat mat.
5. Then put the Gauze mat on top of the tripod.
Equipment needed:
Tips:
Questions:
Thursday, July 8, 2021
Art (clay)
Hi everyone, this week we were making clay people i did have a photo but i cant find it so sorry but here are some of my friends :
My Flappy Bird Game
This is my game there is going to be a link and a QR-Code Here it is :
Click this to take you to the game
------------------------------------------------
I Hope This QR-Code Works
If you played my game hope you like it
Hands on Fire
Aim:
I want to safety light my hands on fire.
Activity : In pairs
Instructions:
1. Collect your equipment.
2. Put some water into a tray.
3. Put some detergent into the water.
4. Put on your safety glass's on.
5. Tie up any long hair.
6. Take off any jewelry.
7. Wet your hands, wrists and arms.
8. Bubble the gas in the water.
9. Scoop the bubbles but not in water.
10. Hold bubbles in front of your face with your arms locked.
My senses:
I saw fire on peoples hands
I felt scared
I heard wow and Screaming
I smelled smoke and a soap
Skittles - Science
Aim :
To use water to extract the dye from skittles using the process of chromatography.
Materials :
- 5 Skittles
- Water or milk
- Petri dish
- Beaker
Process :
- Place the skittles into the petri dish around the edges
- Pour 100ml water gently into the middle of the petri dish
- Then watch the colors spread around the dish until is done
- When its done you can tip it out down the sink
Flooding in Caterbury
Hi everyone this week there was been a Major Flooding Storm!
There where lots of Lighting strikes, Flooding, Severe rain, Earthquakes, Evacuates every where, Closed roads, Instead of normal doing to Dunedin from Christchurch it now 974km to get there because of the flooding. There is also A Code-Red in Metservice. And there has been 3 or 4 earthquakes in the storms and stuff and the storm comes back on Saturday this week but it might not. Also avoid travel as SH1 hinds River bridge is Closed, due to flooding.
Canterbury flooding: Thousands in Ashburton prepare to evacuate
Cyberbullying
Hi everyone this blog is about cyberbullying did you know that you can be fined $50,000 dollars for doing cyberbullying and also its really mean what you can do with cyberbullying too
Bullying free NZ – Cyberbullying
Traditional- existing in or as part of a tradition; long-established.: "the traditional festivities of the Church year".
Cyber- relating to or characteristic o f the culture of computers, information technology, and virtual reality.: "the cyber age".
bullying-seek to harm, intimidate, or coerce (someone
perceived as vulnerable).
Complex- consisting of many different and connected parts.: "a complex network of water channels".
Anonymous- (of a person) not identified by name; of unknown name.: "the donor's wish to remain anonymous" "an anonymous phone call" "the anonymous author of Beowulf".
Unflattering- not flattering.: "the reviews of the book were very unflattering" "an unflattering portrait".
Compounded- makeup (a composite whole); constitute.
Imbalance- lack of proportion or relation between corresponding things.: "tension is generated by the imbalance of power" "the condition is caused by a hormonal
Boundaries- a line that marks the limits of an area; a dividing line.: "the eastern boundary of the wilderness" "the boundary between the US and Canada" "a boundary wall".
Harmful- causing or likely to cause harm.: "sugars that can be harmful to the teeth" "shield the planet from harmful cosmic rays".
Imprisoned- kept in prison: captive.: "an imprisoned dissident".
Penalties- a punishment imposed for breaking a law, rule, or contract.: "the charge carries a maximum penalty of ten years' imprisonment".
Multiple- having or involving several parts, elements, or members.: "multiple occupancy" "a multiple birth".
Locations- a particular place or position.: "the property is set in a convenient location".
Permanent- lasting or intended to last or remain unchanged indefinitely.: "a permanent ban on the dumping of radioactive waste at sea" "damage was not thought to be permanent" "some temporary workers did not want a permanent job".
Unpleasant- causing discomfort, unhappiness, or revulsion; disagreeable.: "an unpleasant smell" "the symptoms are extremely unpleasant".
Restrict- put a limit on; keep under control.: "some roads may have to be closed at peak times to restrict the number of visitors".
Comply- (of a person or group) act in accordance with a wish or command.: "we are unable to comply with your request".
My example of Traditional Bullying:
Hitting people over and over, Making fun of people.
My example of Cyberbullying:
Making fun of people online, sending mean comments.
I've listed 6 reasons why cyberbullying has fewer boundaries than traditional bullying.
i) Quickly, shared, spread and viewed
ii) Stored in multiple locations
iii) Created and shared automatically
iv) Stored in a way that only certain groups can see
v) Shared and posed at any time of the day or night
vi) Left as a permanent record (eg, photos posted on the internet.
4. List 3 key points the law says about harmful digital communications.
i) It’s an offence to send messages and post material online that deliberately cause serious emotional distress. If found guilty you can be imprisoned for up to two years and fined up to $50,000 for individuals, or up to $200,000 for companies.
5. I made a Cyberbullying Poster.